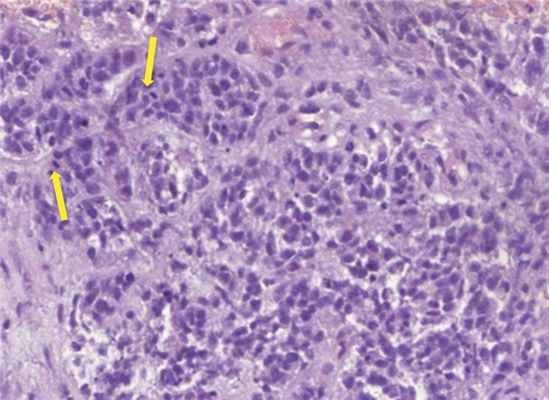

МРТ при опухоли оболочки периферического нерва
Добавил пользователь Дмитрий К. Обновлено: 07.01.2026
Новообразования спинного мозга являются далеко не самыми часто встречающимися опухолями у собак. Но в связи с тем, что МРТ диагностика очень активно набирает обороты в ветеринарном мире, статические цифры сильно изменились по частоте встречаемости данной патологии за последние 20 лет. Новообразования спинного мозга часто являются первопричиной неврологического дефицита у собак. Вероятно, по причине того, что основным методом лечения опухолей спинного мозга является хирургия, данные новообразования классифицируются по локализации поражения к спинному мозгу:
- Экстрадуральные
- Интрадуральные экстрамедуллярные
- Интрамедуллярные
Инцидентность
Из общего числа новообразований, поражающих спинной мозг, преобладают экстрадуральные, они составляют до 50%, доля интрадуральных экстрамедуллярных не превышает 30%, а интрамедуллярных – 15% [4, 9].
Чаще всего новообразования, поражающие спинной̆ мозг, встречаются у собак. Считается, что наиболее распространённым новообразованием такого рода у собак является менингиома [9]. Обычно менингиомы обнаруживают у собак области шейного отдела спинного мозга [9]. Первичные новообразования спинного мозга чаще встречаются у молодых собак в возрасте от 6 месяцев до 3 лет и располагаются, как правило, интрадурально экстрамедуллярно [10, 11]. Самой распространенной вторичной опухолью спинного мозга является гемангиосаркома [12].
первичные опухоли позвонков
- остеосаркома, хондросаркома, фибросаркома, гемангиосаркома, гемангиоэндотелиома и миелома
- метастатические опухоли костей и мягких тканей
- лимфомы, липосаркомы[1, 2, 6, 8,13].
Интрадуральные экстрамедулярные опухоли:
Менингиомы и опухоли оболочки периферических нервов [3]. По данным одного из исследований, 14% всех менингиом, поражающих ЦНС, располагались в спинном мозге (40% в шейном, 32% в грудном и 28% в поясничном отделе) [6].
В другом исследовании у 13 собак с менингиомами спинного мозга 3 локализовались в поясничном отделе спинного мозга и 10 – в шейном [3]. Обзор опухолевых поражений оболочек спинномозговых нервов свидетельствует о том, что в 39 из 60 случаев был поражен спинной мозг [7].
- новообразования, происходящие из глиальных клеток: астроцитома, олигодендроглиома, также встречаются недифференцированная саркома, эпендимома и папиллома хориоидного сплетения, гемангиосаркома, лимфома [1]
- метастатические новообразования, аденокарциномы молочных желез и меланомы [8].
Клиническая симптоматика и диагностика
Доминирующим клиническим симптомом при опухолях спинного мозга является неврологическая симптоматика. Диагностика опухолей спинного мозга, позвоночного столба и метастатического поражения, сводится к установлению локализации компрессирующего компонента и его морфологической верификации. Ограниченные сроки от первых неврологических симптомов до пара-тетраплегии конечностей, диктуют активное проведение неврологического обследования, так как лечение пациентов с сохранившейся способностью к передвижению менее обременительно для владельцев животного и более перспективно для самого животного. Параплегия тазовых конечностей, атрофия мышц, самопроизвольная дефекация и мочеиспускание с неполным опорожнением мочевого пузыря приводят к пролежням в области большого вертела бедренной кости, атонии мочевого пузыря, хроническому циститу [15].
Особенностью клинической симптоматики опухолевого поражения спинного мозга, отличающейся от других случаев компрессионного поражения спинного мозга, является прогрессирующий неврологический дефицит, у собак средних и крупных пород старше 6 лет. В некоторых случаях, грыжа межпозвонкового диска, протекающая по Хансен тип 2, может иметь схожее течение [15]. Клинические признаки могут постепенно нарастать в течение длительного периода времени (от нескольких недель до нескольких месяцев). Однако острое развитие неврологической дисфункции тоже встречается, что может быть связано с ишемией или, наоборот, геморрагией. Интромедуллярные новообразования, которые обычно характеризуются более быстрым ростом, чаще могут приводить к некрозу, геморрагии (или) ишемии [12].
Рентгенологическое исследование самый доступный и наиболее простой из методов дополнительной диагностики, при помощи которого можно исключить травмы позвоночного столба, дискоспондилит, анкилозирующий спондилез, остеохондрозные поражения позвоночного столба, опухоли тела позвонка и в редких случаях дископатию [15]. В остальных случаях приходиться использовать более чувствительные методы визуальной диагностики, такие как МРТ. При этом необходимо понимать, что зачастую мы можем выявить область поражения по рентгену при вовлечении в опухолевый процесс тел позвонков, но оценка степени инвазии в окружающие ткани возможно только по результатам мрт исследования.
Обязательным этапом при выявлении подозрения на рентгене позвоночника или по клинической симптоматики на наличие опухолевого процесса является проведение рентгена грудной клетки трех проекциях и узи брюшной полости с целью исключения отдаленных метастазов.
Миелография позволяет с достаточной точностью локализовать и определить протяженность опухоли спинного мозга. На основании миелографии новообразования классифицируют на экстрадуральные, интрадуральные экстрамедуллярные и интрамедуллярные. Данный метод особенно актуален в случае недоступности метода мрт-диагностики [14].
Лечение
Выбор метода лечения зависит от локализации, объема и вида опухоли. Поэтому после проведения мрт диагностики обсуждается дальнейший план лечения пациента и додиагностики. В случае резектабельности опухоли проводится полноценная операция и последующие гистологическое исследование опухоли. В случае обширного опухолевого поражения проводится по возможности декомпрессия спинного мозга и взятие биопсии или только взятие биопсии с целью получения окончательного диагноза, обсуждения дополнительных методов воздействия на опухоль и дальнейших прогнозов. В качестве дополнительных методов воздействия на опухоли спинного мозга используется химиотерапии в случае лимфом, а также лучевая терапия. Однако основной проблемой лучевой терапии является то, что спинной мозг получит ту же дозу радиации, что и опухоль, и впоследствии проявляется выраженном отеком спинного мозга и как следствием острой болевой реакцией.
Прогноз
Основным прогностическим фактором является резектабельность опухоли, от типа опухоли и от тяжести неврологического расстройства [5]. В одном из исследований 5 из 9 собак жили более 6 месяцев после хирургической резекции менингиомы [3]. Из этих 5 собак 1 прожила более 3 лет.
В условиях нашего центра за 5 лет проведено 5605 мрт исследований позвоночного столба у собак и кошек, из них выявлено в 4,7% исследований выявлен опухолевый процесс: новообразование тел позвонков — 84 животных (31%); новообразование спинного мозга и его оболочек — 141 случаях (53%). 21 животному (19 собак и 2 кошки), что составляет 8% от 268, было проведено оперативное вмешательство в условиях нашей клиники и подтвержден диагноз. Из 19 собак 3 метисы (16%), 3 лабрадор-ретриверы (16%), 2 пудели (11%) и 11 животных (57%) другие породы. Кошки являлись представителями смешанных пород. У 12 (57%) животных было выявлено поражение спинного мозга в шейном отделе позвоночника, у 9 (43%) — в поясничном отделе. В 8 случаях из 21 локализация образований была экстрадуральная (38%), в 12 — интрадуральная-экстрамедуллярная (57%) и в 1 случае интрамедуллярная (4,7%). По результатам гистологических исследований у 4 животных неоплазия не подтвердилась, у одного животного гистологический материал на обследование не был отправлен (интраоперационно киста). Из оставшихся 17 результатов гистологического исследования 5 — менингиома (29%), 4 — лимфома (23%), 2 — хондросаркома (12%) 3 — саркома(18%), 1 -хордома (6%) и 1 — эпендимома(6%), 1- опухоль периферических нервов (6%). По данным нашей статистики, в 5% случаев у пациентов с неврологической симптоматикой были выявлены признаки неопластических изменений, что должно иметь важное значение в предварительной дифференциальной диагностике таких пациентов;
МРТ при опухоли оболочки периферического нерва
МРТ при злокачественой опухоли оболочки периферического нерва (ЗООПН)
а) Терминология:
• Злокачественная опухоль оболочек периферических нервов (ЗООПН)
• Саркома мягких тканей, исходящая из оболочек периферических нервов или клетки которой имеют признаки дифференцировки в клетки этих оболочек
б) Визуализация злокачественной опухоли оболочки периферических нервов (ЗООПН):
• КТ и МРТ: крупное инфильтративное образование мягких тканей, нередко с очагами кровоизлияний:
о Развивается спонтанно или является результатом злокачественной трансформации исходно существующей нейрофибромы
о Неоднородная структура опухоли, соответствующая кальцинатам, очагам кровоизлияний, некрозов
о Эрозии и деструкция костных структур
о Выраженное контрастное усиление
о Нечеткие границы
• ПЭТ с ФДГ позволяет диагностировать ЗООПН при нейрофиброматозе 1 типа с чувствительностью 89% и специфичностью 95%:
о КТ характеризуется гораздо более низкой точностью по сравнению с ПЭТ в отношении характеристики опухолей как злокачественных так и доброкачественных
(Слева) Злокачественные опухоли оболочек периферических нервов (ЗООПН) нередко поражают крупные нервные стволы. Здесь, например, представлена опухоль седалищного нерва, представляющая собой веретеновидной формы дольчатое интраневральное образование. Эти опухоли могут распространяться вдоль оболочек нерва и образовывать сателлитные узелки.
(Справа) На фронтальном FS Т1-ВИ с КУ представлено массивное неравномерно накапливающее контраст объемное образование правой половины таза, распространяющееся через крестцовое отверстие в спинномозговой канал и через седалищную вырезку в ягодичную область. (Слева) Аксиальный срез, Т1-ВИ с КУ: гантелеобразной формы опухоль шейного отдела позвоночника. Видны признаки инфильтрации опухолью паравертебральных мягких тканей и инвазии опухоли в паренхиму спинного мозга.
(Справа) Аксиальный срез, Т1-ВИ с КУ, пациент с НФ1: нейрофибромы (НФ) в просвете левого неврального отверстия и спинномозгового канала. Накапливающая контраст опухоль в толще правой крестцово-остистой мышцы отличается несколько нечеткими границами и является гистологически верифицированной ЗООПН.
в) Дифференциальная диагностика:
• Доброкачественная опухоль оболочек периферических нервов
• Другие саркомы мягких тканей
• Гематома
г) Патология:
• Частота в общей популяции: 0,001%
• 50-60% случаев этих опухолей связаны с нейрофиброматозом 1 типа (НФ1)
д) Клинические особенности злокачественной опухоли оболочки периферических нервов (ЗООПН):
• Растущее образование мягких тканей
• Локальный или корешковый болевой синдром, чувствительные нарушения
• Парапарез
• Спорадические случаи злокачественной опухоли оболочки периферических нервов (ЗООПН) диагностируются в четвертом десятилетии жизни (средний возраст 39,7 лет)
• При сочетании с НФ1: 26-42 года (средний возраст 28,7 лет)
• Местные рецидивы: 26-65%; метастазирование: 20-65%
• Менее благоприятный прогноз при НФ1
Опухоли периферической нервной системы

Опухоли нервной системы – поражение периферических нервов («каналов связей») между центральной нервной системой (спинным и головным мозгом) и внутренними органами. Даже несущественные повреждения нервных окончаний чреваты серьезными последствиями. Периферическая нервная система проводит эфферентные (двигательные, мотонейроны) и афферентные (чувствительные, сенсорные) нервные импульсы, отвечает за координацию движений и построение образов. В ПНС могут развиваться опухоли доброкачественного и злокачественного характера.
Симптомы опухолей периферической нервной системы

Интенсивность клинических симптомов опухолей нервной системы зависит от области локализации новообразования и функционального предназначения пораженного нерва. Типичный признак болезни опухоли периферических нервов – плотно округло-овальное образование, которое смещается в стороны от нервного ствола.
Среди основных симптомов опухолей периферической нервной системы следует выделить:
- снижение чувствительности пораженного участка;
- интенсивные «стреляющие» боли;
- вазомоторные дисфункции (покраснение, прилив крови, местное повышение температуры);
- функциональные нарушения, например паралич;
- ухудшение питания (трофики), чревато ухудшением внешнего вида кожи, снижением эластичности и прочности.
Если нервная проводимость не восстанавливается на протяжении длительного времени, тогда возможно развитие некротических и атрофических процессов и остеопороза (истончения костных структур).
Причины возникновения опухолей нервной системы
- результат деления клеточных структур разных тканей, которые входят в структуру нерва;
- хроническое воздействие химических соединений и радиации;
- проживание в регионах с загрязненной экологической обстановкой.
Также было установлено влияние биологического фактора – воздействия отдельных вирусов на организм человека. Причиной также является снижение противоопухолевой защиты иммунной системы.
Постановка диагноза при опухолях нервной системы
Среди основных диагностических мероприятий следует выделить:
- УЗИ периферических нервов;
- КТ, МРТ и рентгенографию;
- ЭМГ (электромиография);
- диагностика нервной проводимости.
На основании полученных результатов врач определяет стадию развития патологического процесса и область его локализации. Первичные опухоли нервной системы проще поддаются лечению. В случае метастазирования прогноз ухудшается.
Лечение опухолей нервной системы в клинике «Медскан»
Доброкачественные новообразования поддаются консервативной терапии, но только на начальных этапах прогрессирования. Для повышения эффективности принятых мер назначаются физиопроцедуры (ультразвук, электрофорез). Если имеет место выраженный болевой синдром, тогда назначается новокаиновая блокада.
Хирургическое вмешательство необходимо при отсутствии эффективности от консервативного лечения, при злокачественных опухолях, признаках прямой компрессии и прогрессирующем атрофическом парезе. Если рак развивается стремительно, тогда возникает необходимость в ампутации конечности. После операции проводится лучевая и химиотерапия.
Злокачественные опухоли периферической нервной системы опасны тем, что 5-летняя выживаемость является достаточно низкой. Причиной является аксиальное внутриствольное распространение раковых клеток. Метастазы идут в печень и в легкие. Химио- и лучевая терапия при этом дают низкие результаты.
При опухолях нервной системы смерть наступает преимущественно при развитии осложнений. Отсутствие терапии чревато появлением кровотечения, что приводит к анемии. Среди осложнений также следует выделить частичную потерю слуха, зрения и ухудшение дыхательных функций. Смерть может наступить в результате асфиксии (удушения).»
МРТ при опухоли оболочки периферического нерва
ФГБНУ «НИИ нейрохирургии им. акад. Н.Н. Бурденко», Москва, Россия
ФГБУ "НИИ нейрохирургии им. акад. Н.Н. Бурденко" РАМН, Москва
Злокачественная опухоль оболочек периферических нервов, развившаяся из слухового нерва: случай из практики и обзор литературы
Журнал: Журнал «Вопросы нейрохирургии» имени Н.Н. Бурденко. 2017;81(4): 95‑100
НИИ нейрохирургии им. акад. Н.Н. Бурденко РАМН, Москва
Авторами представлен редкий случай наблюдения пациентки со злокачественной опухолью периферического нерва, развившейся из слухо-вестибулярного нерва, а также обзор литературы, включающий 30 известных случаев данной патологии.
НИИ нейрохирургии им. акад. Н.Н. Бурденко РАМН, Москва
ФГАУ «НИИ нейрохирургии им. акад. Н.Н. Бурденко» Минздрава России, Москва, Россия
ФГБУ "НИИ нейрохирургии им. акад. Н.Н. Бурденко" РАМН, Москва
ФГБНУ «НИИ нейрохирургии им. акад. Н.Н. Бурденко», Москва, Россия
ФГБУ "НИИ нейрохирургии им. акад. Н.Н. Бурденко" РАМН, Москва
Список сокращений:
MPNST — злокачественная опухоль оболочек периферических нервов
МРТ — магнитно-резонансная томография
КТ — компьютерная томография
Злокачественная опухоль оболочек периферических нервов — malignant peripheral nerve sheath tumor (MPNST) относится к редкой и гетерогенной группе мезенхимальных злокачественных новообразований, рассматриваемых в большинстве публикаций как саркоматозный процесс. Эта группа опухолей составляет 5—10% всех сарком мягких тканей, с примерной частотой встречаемости 1 человек на 1 млн населения в год [1—4].
Последняя редакция морфологической классификации ВОЗ определяет два подтипа злокачественных опухолей оболочки периферического нерва: эпителиоидная MPNST и MPNST с периневральной дифференциацией, которые признаются достаточно различными по клиническому течению. Другие подтипы MPNST, такие как опухоль Тритона, железистая MPNST и др., которые ранее рассматривались отдельно, в настоящее время расцениваются как гистологические варианты [5]. MPNST могут развиваться как первично из клеток оболочки периферического нерва, так и при малигнизации нейрофибром и шванном [3]. Большинство MPNST развивается в толще мягких тканей из проксимальных частей периферических нервов верхних и нижних конечностей. Наиболее часто поражаются седалищные нервы, плечевое сплетение, крестцовое сплетение. Черепные нервы являются источником роста опухоли в менее чем 5% случаев [3, 6, 7]. Из интракраниальных MPNST чаще поражаются лицевой и слуховой нервы [2, 4]. На 1041 вестибулярную шванному приходится 1 случай MPNST слухового нерва [1]. До 50% MPNST развиваются у пациентов с нейрофиброматозом [8, 9].
Стоит отметить, что литературы по интракраниальным MPNST, в частности по опухолям, происходящим из акустико-фациальной группы нервов, крайне мало. В основном публикации представляют «случай из практики», и лишь в единичных работах анализируются серии наблюдений [1, 4].
Основными факторами риска возникновения MPNST являются нейрофиброматоз 1-го типа и предшествующее радиологическое лечение. В 8—13% случаев у пациентов с НФ 1-го типа в течение жизни развивается MPNST [10]. Большинство источников литературы [8, 9] представляют случаи малигнизации доброкачественных неврином или нейрофибром. Риск трансформации вестибулярной шванномы в MPNST после проведения радиологического лечения составляет от 1/500 до 1/2000 случаев [11—13]. В единичных исследованиях [4, 13—15] сообщается о развитии MPNST без предшествующего лучевого лечения.
Дифференциальный диагноз MPNST включает невриному, параганглиому, гемангиому, эпендимому, ангиолипому, солитарную фиброзную опухоль, лимфому, гемангиоперицитому, каверному, атипичную или анапластическую менингиому, бифросаркому, синовиальную саркому, меланому.
Метастазирование MPNST осуществляется как гематогенным путем, так и с током ликвора [6].
Лечение пациентов с данной патологией включает в первую очередь хирургическое удаление опухоли. Цель хирургического вмешательства — тотальное удаление, но и оно не предотвращает рецидива. В большинстве случаев радикальное удаление выполнить не удается ввиду инфильтративного роста опухоли. Радикальность в этом случае приводит к грубой инвалидизации или летальному исходу. Оперативное лечение необходимо дополнять лучевой терапией. Применение химиотерапии и ее эффективность оспариваются частью специалистов [1, 6].
Наиболее современное исследование, посвященное MPNST, представляет анализ 24 случаев MPNST слухового нерва, возникших без предшествующего хирургического и лучевого лечения [1]. Распределение пациентов по полу в серии наблюдений было равнозначное. Средний возраст пациентов на момент установления диагноза составил 44 года, что было примерно на 10 лет меньше, чем при спорадической вестибулярной шванноме [1, 16]. В клинической картине заболевания, помимо кохлеовестибулярного синдрома, выявлялся паралич лицевого нерва. По данным нейровизуализации определялись такие признаки, как нечеткость границ опухоли, отек ствола головного мозга, полости распада в опухоли [1].
Прогноз у пациентов с MPNST крайне неблагоприятный. Медиана продолжительности жизни с момента установления диагноза составляет 3 мес. Наиболее значимыми факторами, влияющими на эффективность лечения, признаются тотальное удаление, радиотерапевтическое лечение, женский пол [17].
Клиническое наблюдение
Пациентка К., 19 лет, поступила 02.03.16 в ННПЦН им. акад. Н.Н. Бурденко с жалобами на головокружения, боль в лице и области уха, слабость лицевой мускулатуры, сильную головную боль, тошноту и рвоту, двоение предметов перед глазами, онемение на лице.
Появление первых симптомов — сильной стреляющей боли в правом ухе и головокружений — отмечено 17.11.15 на фоне острой респираторной инфекции. Через 3 дня присоединилась сильная головная боль с тошнотой, рвотой, стал быстро снижаться слух на правое ухо. Впервые выполненная МРТ головного мозга 27.11.15 показала изменения в области правого внутреннего слухового прохода.
В результате выполненной 02.12.15 МРТ головного мозга с контрастным усилением, показавшей наличие интраканальной опухоли, распространяющейся в сторону мостомозжечковой цистерны, заподозрена невринома слухового нерва. Было принято решение проводить динамическое наблюдение. Однако 14.12.15 остро развилась слабость лицевой мускулатуры, стала нарастать интенсивность головокружений. Внепланово была выполнена контрольная МРТ головного мозга 13.01.16, где отмечалось увеличение экстраканальной части опухоли почти в 2 раза. В течение подготовки к хирургическому лечению отмечалось значительное ухудшение состояния: нарастание статодинамических нарушений, увеличение выраженности симптоматики со стороны правого мостомозжечкового угла, появление бульбарных нарушений, выраженных общемозговых симптомов. По МРТ головного мозга от 22.02.16 отмечалась прогрессия экстраканальной части опухоли до 3 см. На фоне терапии глюкокортикоидами, обезболивающими и противорвотными препаратами состояние пациентки стабилизировалось.
Пациентка поступила в ННПЦН им. акад. Н.Н. Бурденко в тяжелом состоянии. В клинической картине заболевания выявлялась развернутая симптоматика поражения правого мостомозжечкового угла в виде недостаточности тройничного, лицевого (паралич лицевой мускулатуры справа), слухового (глухота) нервов, бульбарных нарушений, правосторонней гемиатаксии. Также выявлялась выраженная общемозговая симптоматика, представленная головной болью, тошнотой и рвотой, локальными болями в области уха.
Учитывая темп развития симптомов, был заподозрен злокачественный характер опухоли. В день поступления (02.03.16) пациентке выполнена МРТ головного мозга и спинного мозга с контрастным усилением. Была выявлена диссеминация процесса с появлением опухоли в левом внутреннем слуховом проходе, множественных очагов патологического накопления контрастного вещества оболочек спинного мозга. Динамика распространения первичного очага и метастазирование представлены на рис. 1 и 2.

Рис 2. МРТ от 02.03.2016 - метастазирование опухоли по оболочкам спинного мозга (указаны стрелками).
Учитывая распространенность патологического процесса, низкий уровень статуса по шкале Карновского (40 баллов), было принято решение о паллиативной операции — расширенной декомпрессии задней черепной ямки от правого сигмовидного синуса до середины левой гемисферы мозжечка и краниовертебрального перехода, частичном удалении опухоли с экспансивной пластикой твердой мозговой оболочки.

Рис. 3. Рис 3. КТ головного мозга, выполненная на 6-е сутки после операции. Признаки быстрого продолженного роста опухоли.
Таким образом, от появления симптомов до выявления опухоли на МРТ головного мозга прошло 10 дней, а длительность заболевания до летального исхода составила 136 дней.
Морфологическое исследование выявило злокачественную опухоль с кровоизлияниями и некрозами. Опухоль состояла из биполярных клеток с удлиненными отростками и овальными полиморфными ядрами, клетки местами формировали альвеолярные структуры. Фигуры митозов были видимы даже при относительно небольшом увеличении (рис. 4). Иммуногистохимическое исследование выявило: положительную экспрессию эпителиальных маркеров — цитокератина АЕ1/3 (+++) и эпителиального мембранного антигена EMA (++), гладкомышечного актина SMA (++), синаптофизина syn (+) в опухолевых клетках; экспрессию CD34 (+) в эндотелии сосудов. Экспрессии S100, глиофибриллярного кислого белка GFAP, общего лейкоцитарного антигена CD45 в опухолевых клетках не выявлено. Также в опухолевых клетках отсутствовала экспрессия INI1 при сохранной экспрессии антитела в эндотелии сосудов (рис. 5). Индекс мечения пролиферативного маркера Ki-67 — более 90% (рис. 6). Проводился дифференциальный диагноз между атипической тератоидно-рабдоидной опухолью, эпителиоидной саркомой, эпителиоидной злокачественной опухолью оболочек периферического нерва. Заключение: учитывая возраст, характер роста и распространение опухоли, иммуногистохимические данные более соответствуют диагнозу «эпителиоидная злокачественная опухоль периферического нерва (WHO grade IV)». Аутопсия не производилась.
Рис. 4. Гистологический препарат опухоли. Окраска гематоксилином и эозином, увеличение Х300. Альвеолярные структуры и митозы (указаны стрелками).

Рис. 5. Гистологический препарат опухоли. Иммуногистохимическое исследование, увеличение Х300. Отсутствие экспрессии INI1 в ядрах опухолевых клеток при сохранной экспрессии в эндотелии сосудов (внутренний контроль корректной работы антитела).

Рис. 6. Гистологический препарат опухоли. Иммуногистохимическое исследование, увеличение Х200. Высокий индекс мечения пролиферативного маркера Ki-67.
MPNST являются малоизученными опухолями, что связано с низкой частотой встречаемости (очень редко встречается MPNST слухо-вестибулярного нерва) и крайне неблагоприятным исходом. Выраженность симптоматики уже на ранних стадиях заболевания зачастую помогает диагностировать опухоль, когда она небольших размеров. Дифференциальный диагноз, в частности с невриномой слухового нерва, создает трудности в планировании оперативного лечения. К моменту операции пациенты имеют опухоли большого размера и признаки метастазирования по центральной нервной системе. Оперативное лечение на ранних этапах при условии радикального удаления и проведения последующей лучевой терапии увеличивает продолжительность жизни от 1 года до 3 лет. При отсутствии оперативного лечения в среднем через 3 мес после начала заболевания наступает летальный исход. Применение химиотерапии в настоящее время оспаривается.
Заключение
MPNST, развивающаяся из VIII пары черепных нервов, является редкой опухолью, представляющей большие трудности в хирургическом удалении и последующем адъювантном лечении. Отсутствие хирургического лечения приводит к летальному исходу в короткие сроки. Даже тотальное удаление опухоли не предотвращает развития рецидива. Прогноз заболевания неблагоприятный.
Авторы заявляют об отсутствии конфликта интересов.
Комментарий
Опухоли периферических нервов
В структуре неврологических заболеваний патология периферической нервной системы составляет около 50%, занимая при этом первое место по степени утраты трудоспособности. Одной из наиболее часто встречающихся групп заболеваний периферических нервов конечностей являются тоннельно-компрессионные синдромы. Эти заболевания встречаются довольно часто (до 45%) у лиц, профессиональная деятельность которых связана с длительным напряжением отдельных групп мышц.
Тоннельно-компрессионный синдром.
Исходя из локализации и характера патологического процесса выделяют следующие группы заболеваний.
- Поражения черепных нервов (включая невралгию тройничного нерва, атипичную лицевую боль, паралич лицевого нерва, гемифациальный спазм, языкоглоточную невралгию и т.д.).
- Поражения нервных корешков и сплетений (включая поражения плечевого сплетения, пояснично-крестцового сплетения, фантомный болевой синдром, сдавление нервных корешков при патологии позвоночника).
- Тоннельные синдромы периферических нервов (включая синдром запястного канала, поражения локтевого нерва, синдром верхней грудной апертуры, парестетическую мералгию, синдром предплюсневого канала, поражения седалищного нерва и т.д.).
- Нейропатии при системных заболеваниях (эндокринных, аутоиммунных).
В организме человека существуют зоны повышенной ранимости периферических нервов, проходящих по особым каналам или тоннелям, образованным костями, мышцами, связками и фасциями. При патологических изменениях в тканях, образующих стенки тоннеля, возникает ирритация и компрессия нервов.
К этиологическим факторам относятся профессиональная или бытовая нагрузка на мышцы и фасции в районе тоннеля (хроническая микротравматизация), травматические поражения костей и мягких тканей, аномалии и варианты строения тканей, а также системные заболевания (эндокринопатии, болезни обмена, полиартриты ревматической и иной природы), сопровождаемые морфологическими изменениями в области тоннеля.

Клинические проявления тоннельного синдрома.
В ранний период заболевания правильный диагноз тоннельного поражения ставят редко! Это обусловлено преобладанием симптомов раздражения над симптомами выпадения.
Обычно клиническая картина тоннельного синдрома складывается из следующих симптомов.
- Наличие спонтанных парестезий (покалываний, чувства «мурашек») в зоне иннервации пораженного нерва. Как правило, парестезии возникают в ночное время, что связано с развитием венозного застоя в дистальных отделах конечности во время сна. Венозный застой, в свою очередь, способствует нарушению локального кровообращения в районе тоннельного поражения нерва.
- Спонтанные боли также типичны для туннельного поражения нерва. Наблюдается широкий диапазон характера и интенсивности спонтанных болевых ощущений – от нерезко выраженных тупых болей в области туннеля до острых болей, не позволяющих производить даже небольшой объем движений в суставах по соседству с туннелем. Характерна иррадиация боли в зоне иннервации нерва.
- У подавляющего большинства больных выявляются расстройства чувствительности в виде участков гипестезии и гипалгезии в зоне иннервации соответствующего нерва, реже – участки гипералгезии и гиперпатии. Появление расстройств чувствительности на поздних стадиях заболевания обусловлено медленным нарастанием тканевого давления в области туннеля. Если же острое туннельное поражение нерва возникает вследствие компрессии структурами, образующими туннель, расстройства чувствительности развиваются относительно быстро.
- Двигательные нарушения наблюдаются реже нарушений чувствительности и в подавляющем большинстве случаев – на поздних стадиях заболевания. Они могут проявляться в виде парезов кистей, стоп, иногда отдельных пальцев. Типичны мышечные атрофии.
- Вегетативно-сосудистые нарушения в виде изменения кожной температуры, трофических поражений кожи, волос, ногтей являются частыми проявлениями туннельных синдромов.
Диагностика тоннельного синдрома должна основываться на клиническом осмотре специалистом и дополнительных методах обследования (электомиография, вызванные потенциалы, рентгенография, КТ, МРТ).
Лечение тоннельного синдрома:
- консервативная терапия, включающая лекарственную терапию, физиотерапию, массаж, лечебные физические упражнения и др.;
- хирургическое лечение.
Показания к применению хирургических методов лечения возникают при недостаточном эффекте консервативной терапии и наличии у больных в клинике:
- признаков прямой компрессии нерва костными образованиями, фиброзными структурами, рубцово-спаечным процессом, гематомой или опухолью;
- стойкого выраженного болевого синдрома, снижающего трудоспособность;
- прогрессирующего атрофического пареза нескольких мышц со снижением профессиональной трудоспособности;
- стойких вегетативно-трофических расстройств;
- сочетанных поражений нерва и близлежащих магистральных сосудов, подтвержденных ангиографией или реовазографией с функциональными тестами.
Решение о методе лечения принимается врачом индивидуально в каждом конкретном случае.

Топографическая анатомия n. medianus (4) в нижней трети предплечья, запястном канале и на кисти (в этой области чаще всего возникает синдром запястного канала).
1 — a., v. et n. ulnares; 2 — m. flexor digitorum profundus и m. flexor digitorum superficialis; 3 — vagina synovialis communis mm. flexorum; 4 — n. medianus; 5 — m. abductor digiti minimi; 6, 9 — nn. digitales palmares proprii n. ulnaris; 7 — m. flexor digiti minimi brevis; 8 — arcus palmaris superficialis; 10 — aa. digitaies palmares communes; 11 — mm. lumbricales; 12 — mesotenon; 13 — vaginae synoviales tendinum digitorum; 14 — vagina fibrosa digiti manus; 15 — aa. digitaies palmares propriae; 16 — m. interosseus dorsalis I; 17 — vagina synovialis tendinis m. flexoris pollicis longi; 18 — m. adductor pollicis (caput transversum); 19 — nn. digitaies palmares proprii (n. mediani); 20 — r. superficialis a. radialis; 21 — m. abductor pollicis brevis; 22 — m. flexor pollicis brevis; 23 — nn. digitaies palmares communes (n. mediani); 24 — r. muscularis n. mediani; 25 — a. et v. radialis.
На долю поражений периферической нервной системы приходится 5-10% общего травматизма населения.Травматические поражения периферических нервов являются наиболее частыми причинами тяжелых расстройств двигательных функций, при этом более половины пострадавших становятся инвалидами II-III групп.
Читайте также:
